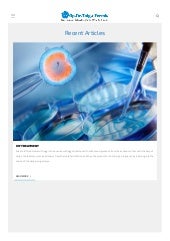

Micro Chip In Vitro Fertilization Treatment Dogus Tup Bebek Merkezi

Mucizelerinize Kavusmaniz Icin Sizleride Opr Dr Fatih Oguc Tup Bebek Tedavisi Uzmani Facebook

Opr Dr Fatih Oguc Tup Bebek Tedavisi Uzmani Postingan Facebook

Mikro Cip Tup Bebek Tedavisi Ozel Ata Saglik Hastanesi

Sperm Icin Mikrocip Yontemi Nedir Nasil Yapilir Ivf Icsi Tup Bebek Tedavisi

Opr Dr Fatih Oguc Tup Bebek Tedavisi Uzmani Postingan Facebook

Mikrocipli Tup Bebek Tedavisi

Tup Bebek Basarisizliginin Nedeni Sperm Kaynakli Olabilir Op Dr Hasan Sanisoglu

Bugun Saat 22 30 Da Merveeoguc Opr Dr Fatih Oguc Tup Bebek Tedavisi Uzmani Facebook

Micro Chip In Ivf Micro Chip In Cyprus Dogus Ivf Fertility Centre

Jinepol Kadin Sagligi Ve Tup Bebek Klinigi Blog

Opr Dr Fatih Oguc Tup Bebek Tedavisi Uzmani Yesilkoy Istanbul Caddesi No 82 Istanbul 2020

Tup Bebek Tedavisinde Neler Degisti

Tup Bebek Merkezi Kibris Sht Sonay Ali Sk No 141 1 Kumsal Lefkosa 2020

Ivox Tup Bebek Merkezi Hospital Nicosia Cyprus 7 Photos Facebook
Tolgaecemis Com Tup Bebek Ankara Ankara Tup Bebek

5wlzrpxr3aw8sm

Mikrocip Yontemi Tup Bebekte Basari Sagliyor Istanbul Haberleri

Tup Bebek Tedavisi

Opr Dr Fatih Oguc Tup Bebek Tedavisi Uzmani Postingan Facebook

Tup Bebek Merkezi Kibris Sht Sonay Ali Sk No 141 1 Kumsal Lefkosa 2020

Tup Bebek Sahibi Aileler Iftarda Bulustu Op Dr Ufuk Yilmaz

Mikrocip Microchip Teknolojisi Gazete Guney

About Us Dogus Ivf Fertility Center Cyprus

Tup Bebek Tedavisinde Mikrocip Yontemi Basariyi Artiriyor Saglik Haberleri

Fertile Plus Mikrocip Yildiz Tup Bebek

Jinepol Kadin Sagligi Ve Tup Bebek Klinigi

Mikrocipli Asilama

Tupbebekuzmani Instagram Posts Gramho Com

Tup Bebek Tedavisi Hakkinda Merak Opr Dr Fatih Oguc Tup Bebek Tedavisi Uzmani Facebook

Tupbebektedavisi Instagram Posts Gramho Com